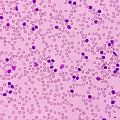
, con

Entre probetasJosé Antonio López Guerrero
Fuera de emisión
'Entre probetas' nació para informar y entretener; entretener divulgando ciencia.
'Entre probetas' trata en poco menos de media hora, y en el tono desenfadado y directo que caracteriza al equipo, lo más destacado de la biología -en todas sus facetas-, medicina, tecnología o cualquier otra rama de la investigación humana. La labor de su director como Profesor e Investigador del Departamento de Biología Molecular de la Universidad Autónoma de Madrid y Director de Cultura Científica de uno de los mejores centros de investigación del país -Centro de Biología Molecular Severo Ochoa- permite estar en primera línea informativa sobre cualquier área del "cienciaverso".